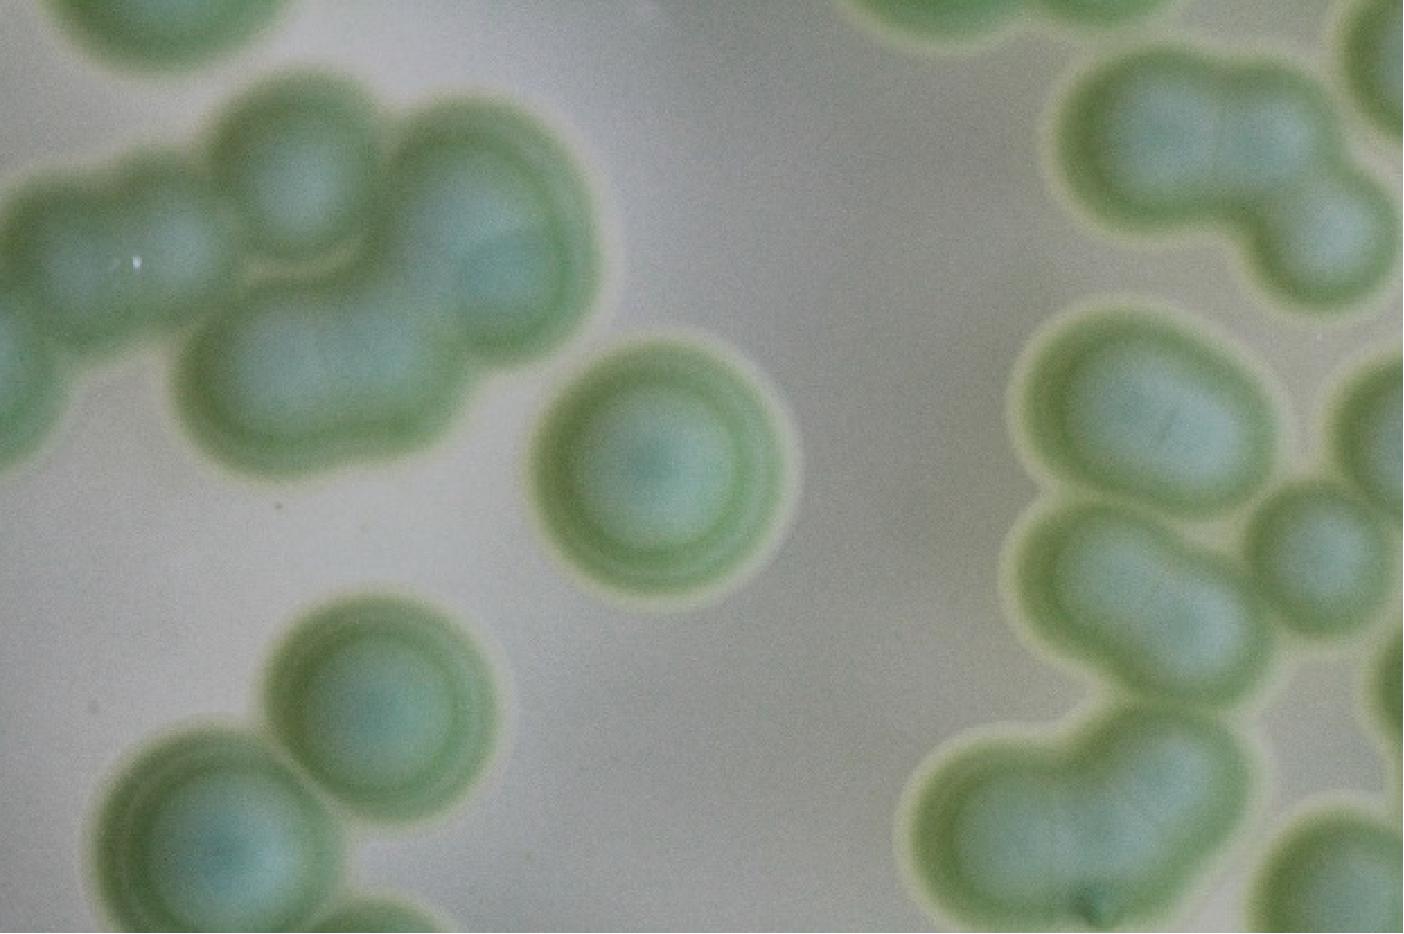

冰酒是一种口感独特馥郁、甘甜的葡萄酒,葡萄通过自然冷冻或延迟采收工艺,在葡萄藤上完成糖分浓缩后精心酿制而成。葡萄在气温不高于-8 ℃的条件下被压榨,并在严格的低温环境中进行发酵,从而赋予了冰酒无与伦比的特质[1]。由于葡萄采收时机的刻意延迟、自然冷冻以及冷浸技术的运用,冰酒相较于其他类型的葡萄酒,含有更为丰富的酸糖度、馥郁的香气以及多样化的风味物质,为品鉴者带来了极致的感官享受[2]。冰酒酿造对环境条件要求极为苛刻,其产区集中于加拿大安大略省、德国莱茵高地及中国东北鸭绿江流域等少数特定区域,而且酒的发酵过程更需要耐受性较好的菌种[3]。集安鸭绿江河谷是中国冰葡萄酒主要产区之一,种植了大面积的葡萄杂交品种——北冰红(V.amurensis×V.vinifera),其具有良好的浆果质量和耐寒性以及稳定的产量[4]。相较于北冰红干酒,北冰红冰酒蕴含着更高浓度的糖分、香气成分及风味物质,展现出更为圆润的口感与醇厚馥郁的香气,是一款具有较高市场价值的冰酒品种[5]。
葡萄酒的独特风味很大程度上源于众多化合物相对浓度的精妙平衡,而这些化合物在发酵和陈酿过程中,经由酵母和细菌等微生物的代谢而得以形成与演变[6],其中酵母菌在发酵过程中具有重要作用[7]。目前,商业酵母因其可靠性、高效性、稳定性以及可控的发酵特性,在葡萄酒酿造领域内被普遍采用,但也导致了葡萄酒风味趋于同质化以及区域特色感官特征的淡化。因此,本地酵母菌种的筛选与培育逐渐获得了更多关注。本地酵母菌种不仅能够通过生成多样化的风味化合物为葡萄酒风味增添独特魅力[8],而且它们对当地的葡萄品种、酿酒厂特有的环境条件以及外部环境因素展现出卓越的适应性。因此,采用本地酵母菌种有助于更好地维护和突显区域冰酒所特有的感官特征和个性,也使产地冰酒成为风土条件的独特代言[9-10]。
酵母菌(Saccharomyces)是一个种类繁多且广泛分布于自然界的单细胞真菌族群,其主要成员可被区分为酿酒酵母(Saccharomyces cerevisiae)与非酿酒酵母(non-Saccharomyces cerevisiae)两大类[11-12]。酿酒酵母是葡萄酒酿造领域的主力军,主导着各类葡萄酒主发酵过程[13-14],在冰酒香气形成中也起着至关重要的作用,会产生多种风味化合物,包括高级醇、酯类、脂肪酸和羰基化合![]() 等[17]研究奥地利白葡萄品种维特利纳的秋季果实和冬季果实以及冰酒原汁中微生物群落结构,结果表明微生物群落中酿酒酵母属种类占比最多,这些菌株表现出较佳的酯酶和β-葡萄糖苷酶活性,对葡萄酒的风味形成至关重要,也为调节冰酒的独特风味提供了有利条件。非酿酒酵母[毕赤酵母属(Pichia)、汉森酵母属(Hanseniaspora)、梅奇酵母属(Metschnikowia)以及克鲁维酵母属(Kluyveromyces)]通过次级代谢途径合成醇类、酯类、酚类及酮类等挥发性香气组分,这些化合物通过协同作用显著增强冰酒的复杂度和感官品质[16,18]。GE等[19]从威代尔冰酒筛选出11株具有代表性的本土非酿酒酵母菌株,这些菌株能够有效地调控并平衡冰葡萄酒中有机酸含量,在发酵过程中还显著提升了多酚的浓度;其中覆膜孢酵母YC30和葡萄汁有孢汉逊酵母QTX22在发酵过程中发挥了关键作用,不仅能够增强威代尔冰酒的甜味,还赋予了酒体更加浓郁的花香,为冰酒的品质提升带来了显著的贡献。
等[17]研究奥地利白葡萄品种维特利纳的秋季果实和冬季果实以及冰酒原汁中微生物群落结构,结果表明微生物群落中酿酒酵母属种类占比最多,这些菌株表现出较佳的酯酶和β-葡萄糖苷酶活性,对葡萄酒的风味形成至关重要,也为调节冰酒的独特风味提供了有利条件。非酿酒酵母[毕赤酵母属(Pichia)、汉森酵母属(Hanseniaspora)、梅奇酵母属(Metschnikowia)以及克鲁维酵母属(Kluyveromyces)]通过次级代谢途径合成醇类、酯类、酚类及酮类等挥发性香气组分,这些化合物通过协同作用显著增强冰酒的复杂度和感官品质[16,18]。GE等[19]从威代尔冰酒筛选出11株具有代表性的本土非酿酒酵母菌株,这些菌株能够有效地调控并平衡冰葡萄酒中有机酸含量,在发酵过程中还显著提升了多酚的浓度;其中覆膜孢酵母YC30和葡萄汁有孢汉逊酵母QTX22在发酵过程中发挥了关键作用,不仅能够增强威代尔冰酒的甜味,还赋予了酒体更加浓郁的花香,为冰酒的品质提升带来了显著的贡献。
本研究采用传统培养分离法结合形态形态学鉴定技术,从北冰红冰酒发酵液中分离纯化天然酵母菌,通过对筛选的天然酵母菌株进行产气、产酯、产乙醇、产β-葡萄糖苷酶等性能研究,结合分子生物学技术筛选出优良酵母菌株,并系统评估这些优选酵母菌株在低温条件下对温度、糖、乙醇、pH的耐受性。旨在发掘并培育出适合冰酒酿造的优质酵母菌,并为北冰红冰酒生产提供具有鲜明本土特色的高品质酵母资源。
1 材料与方法
1.1 材料与试剂
1.1.1 材料
本实验酿酒北冰红葡萄产于中国东北鸭绿江流域集安地区葡萄园(中国吉林省集安市,东经125°34,北纬40°52),收获时间分别为2023年12月1日和2023年12月25日,采收温度为-10~-8 ℃,葡萄果汁糖度(28±5) °Brix。采收后北冰红葡萄在(-8±1) ℃温度下进行压榨,压榨后葡萄汁分别放入5 L发酵瓶中,置于低温培养箱中,在10~12 ℃温度下进行控温发酵。酵母菌分离分别在葡萄破碎后及葡萄酒自然发酵过程的初期、中期、后期3个时期取样。初期从葡萄破碎进罐到发酵启动(此时罐底部有少量气泡向顶部上升);中期即发酵旺盛期(此时葡萄皮渣上升形成“冒”,罐内大量气泡上升);发酵消退期(此时液面又降至初期,发酵醪中无明显气泡上升)。
1.1.2 试剂
磷酸二氢钾、氯化钾、三丁酸甘油酯、溴甲酚绿等均为国产分析纯,国药集团化学试剂有限公司;酵母浸粉、蛋白胨、葡萄糖、琼脂粉、氯霉素、2,3,5-氯化苯基四氮唑、七叶苷、酵母基因组DNA抽提试剂盒、DNA Ladder Mix Maker等均为生化试剂,上海生工生物工程股份有限公司。
1.1.3 培养基
YPD液体培养基、YEPD(yeast extract peptone dextrose medium)固体培养基、沃氏营养琼脂(wallersteins laboratory nurtrient agar,WLN)培养基、氯化三苯基四氮唑(tetrazolium chloride medium,TTC)培养基[20]、产酯筛选培养基[21]、七叶灵培养基[22]。
1.2 仪器与设备
UV-2600紫外可见分光光度计,日本岛津公司;SW-CJ-1F单人双面净化工作台,苏州净化设备有限公司;BSD-100振荡培养箱,上海博讯实业有限公司医疗设备厂;FR980凝胶成像仪,上海复日科技仪器有限公司;3730XL测序仪、2720 thermal cycler型PCR仪,Applied Biosystems;DYCP-31DN DNA电泳槽、DYY-5稳压电泳仪,北京六一仪器厂CKX41-A32FL/PH 荧光倒置显微镜,奥林巴斯(中国)有限公司。
1.3 实验方法
1.3.1 自然发酵酵母菌的分离和纯化
在发酵初期、中期、后期,取0.1 mL自然发酵的北冰红冰酒样品,用无菌去离子水分别稀释至10-10~10-4浓度,取0.05 mL涂布于YEPD平板,28 ℃ 下培养3 d。将每个YEPD平板,随机挑取15~20个单菌落,以划线方式在YEPD平板上分离纯化。纯化3次以上,将纯化后单菌株接种于YPD液体培养基的三角瓶中活化,将活化的菌液与40%(体积分数)的无菌甘油以1∶1(体积比)混合于保藏管中,-70 ℃以下保藏。
1.3.2 酵母菌形态学初步鉴定
将保藏管纯种菌株划线接种于YEPD 斜面上,28 ℃培养2~3 d进行活化。挑取活化好的菌体1环接种YPD培养基的三角瓶中,28 ℃摇瓶振荡培养3 d。取0.05 mL菌液,用无菌去离子水分别稀释至10-12~10-6浓度用于鉴定。
(1)菌落特征鉴定:取0.05 mL涂布于WLN营养培养基,于培养箱中28 ℃下培养3~5 d后观察。
(2)细胞特征鉴定:取少量稀释样品染色,显微镜下观察并记录细胞特征。
1.3.3 优良酵母菌菌株发酵性
将1.3.2节筛选出的菌株接种特定培养基中,于12 ℃和28 ℃下培养4 d,定期观察产气和显色情况。其中,产气性能测定,参照李亚辉等[23]的方法;产酒精性能测定,参照闫兴敏等[24]的方法;产酯性能测定,参照徐丽萍[25]的方法;产β-葡萄糖苷酶性能测定,参照赵林果等[26]的方法。
1.3.4 分子生物学鉴定
将1.3.3节筛选的高产气、高产酒精、高产酯、高β-葡萄糖苷酶的综合特性优良的北冰红冰酒酵母菌菌株进行生物分子学鉴定。采用26S rDNA D1/D2区序列扩增,使用通用引物NL1(5′-GCATATCAATAAGCGGAGGAAAAG-3′)和NL4(5′-GGTCCGTGTTTC AAGACGG-3′)。PCR 扩增后送至生工生物工程(上海)股份有限公司测序。将测序得到的序列与NCBI 数据库进行同源比对分析,并使用MEGA 7.0构建系统发育树。
1.3.5 低温耐受性研究
将1.3.4节鉴定菌株按照3%接种量接种于200 mL YPD液体培养基中,分别进行如下低温耐受性研究。
(1)耐温度性能测定:分别于4、12、20、28、36、44 ℃下培养28 h,在600 nm下测定OD值,以YPD培养基作为空白对照组。
(2)耐糖性能测定:分别接入葡萄糖质量浓度为50、150、250、350、450、500 g/L的培养基中,在12 ℃条件下培养28 h,在600 nm下测定OD值,以未添加葡萄糖YPD培养基作为空白对照组。
(3)耐酒精性能测定:分别接入酒精体积分数为4%、8%、12%、16%、20%、24%的培养基中,在12 ℃条件下培养28 h,在600 nm下测定OD值,以未添加酒精YPD培养基作为空白对照组。
(4)耐pH性能测定:分别接入用乳酸调整培养基pH值为2.5、3、3.5、4、5、6的培养基中,在12 ℃条件下培养28 h,在600 nm下测定OD值,以YPD培养基作为空白对照组。
1.4 数据统计
NCBI中BLAST序列比对结果解释网站:http://www.docin.com/p-545514843.html。采用SPSS Statistics 19对数据进行单因素方差分析(ANOVA),新复极差法(Duncan)测验,检验组间差异显著性。每个处理测定3个重复,结果用“平均值±标准差”表示。
2 结果与分析
2.1 酵母菌分离与纯化
北冰红冰酒自然发酵后分离纯化得到38株菌株酵母,编号为BBH 1~BBH 38。38株菌的菌落均呈现出乳白色的外观,形态相似,表面光滑易于接种环挑起。尽管这些菌落的整体特征相似,但在菌落大小上仍然可以观察到一定的差异。
2.2 酵母菌形态学初步鉴定
WLN培养可以区分葡萄酒发酵过程中绝大多数典型葡萄酒相关酵母菌种,从北冰红冰酒自然发酵后分离纯化得到38株菌株,根据PALLMAN等[27]和黄英子[28]描述的菌落特征进行对照,筛选出了19株酵母菌落形态(图1~图3)。将19株酵母菌株接入YPD培养基,显微镜下观察细胞特征(图4~图6)。通过WLN培养基的筛选,按照其在培养基上的颜色、大小、干燥程度、表面光滑和边缘整齐度等因素,将分离的19株酵母菌初步分为三类,Ⅰ类菌落共8株,编号BBH 3、BBH 6、BBH 9、BBH 12、BBH 17、BBH 20、BBH 22、BBH 32;Ⅱ类菌落共6株,编号BBH 2、BBH 15、BBH 16、BBH 21、BBH 37、BBH 38;Ⅲ类菌落共5株,编号BBH 7、BBH 18、BBH 25、BBH 31、BBH 34。

图1 WLN培养基Ⅰ类菌落特征
Fig.1 Characteristics of type Ⅰ colonies on WLN medium
图2 WLN培养基Ⅱ类菌落特征
Fig.2 Characteristics of type Ⅱ colonies on WLN medium

图3 WLN培养基Ⅲ类菌落特征
Fig.3 Characteristics of type Ⅲ colonies on WLN medium

图4 YPD培养基Ⅰ类细胞特征
Fig.4 Characteristics of type Ⅰ cells on YPD medium

图5 YPD培养基Ⅱ类细胞特征
Fig.5 Characteristics of type Ⅱ cells on YPD medium

图6 YPD培养基Ⅲ类细胞特征
Fig.6 Characteristics of type Ⅲ cells on YPD medium
由图1中Ⅰ类菌落特征可以看出,酵母菌落呈乳白色,中心凸起略有青色圆圈,表面光滑、有光泽、呈奶油状,边缘略带透明环;由图4中Ⅰ类细胞特征可以看出,酵母菌细胞呈圆形,半径约为3.33 μm。由图2中Ⅱ类菌落特征可以看出,酵母菌落中间呈奶油带蓝色,外部呈绿色、扁平、略微球面突起,表面光滑、有光泽、不透明,边缘呈奶油状;由图5中Ⅱ类细胞特征可以看出,酵母菌细胞呈纺锤形,长半径约为3.61 μm,短半径约为2.04 μm。由图3中Ⅲ类菌落特征可以看出,酵母菌落呈奶油状,中间呈浅青色,表面凸起、光滑、有光泽,边缘呈红色,菌落小;由图6中Ⅲ类细胞特征可以看出,酵母菌细胞呈椭圆形,半径为3.02 μm。
2.3 酵母菌菌株发酵性筛选
2.3.1 酵母产气性能
产气速度和产气量的大小可以反映酵母菌的发酵性能。在相同的时间内,产气量越大的酵母菌,其发酵速率越高;产气速度越快,起酵时间越短,酵母菌起酵性能越强[29]。19株酵母菌的产气能力测定结果见表1。由表1可知,在28 ℃培养条件下,BBH 3、BBH 9、BBH 12、BBH 16、BBH 20和BBH 37菌株产气速度最快;除BBH15、BBH18、BBH34、BBH38菌株产气能力较弱外,其余菌株产气能力较好。
表1 酵母菌的产气能力测定结果
Table 1 Measurement results of gas production capacity of yeast strains

分类菌株编号12 ℃28 ℃24 h48 h24 h48 hⅠ类BBH 3++++++++BBH 6-++++BBH 9++++++++BBH 12++++++++++BBH 17+++++++BBH 20++++++++++BBH 22+++++++BBH 32-++++Ⅱ类BBH 2+++++++BBH 15-+++BBH 16++++++++++BBH 21+++++BBH 37++++++++++BBH 38++++Ⅲ类BBH 7++++++BBH 18-+++BBH 25++++++BBH 31++++++BBH 34---+
注:“+、++、+++”分别表示产气达到杜氏小管体积![]() 全部;“-”表示未产气。
全部;“-”表示未产气。
冰酒酵母的发酵温度控制在10 ℃~15 ℃为宜,有利于酵母保持较高的活性,同时保证冰酒中各种风味物质的生成和协调[30]。因此,考察12 ℃培养条件的发酵性有助于筛选适合冰酒发酵的菌种。在12 ℃培养条件下,菌株BBH 12、BBH 16、BBH 20和BBH 37产气速度最快;除菌株BBH 34未产气以及BBH 6、BBH 15、BBH 18、BBH 21、BBH 32和BBH 38产气能力较弱外,其余菌株产气能力较好。综合19株酵母菌产气能力结果分析可知,Ⅰ类菌株和Ⅱ类菌株产气要强于Ⅲ类。Ⅰ类BBH 12和BBH 20,Ⅱ类BBH 16和BBH 37菌株产气能力较强,发酵性能较好,尤其在冰酒低温培养条件下仍具有较好发酵性能。
2.3.2 酵母产酒精性能
在TTC培养基上进行产酒精能力筛选,根据显色情况判定酵母菌产酒精能力的大小[31],19株酵母菌的产酒精能力测定结果见表2。由表2可知,在12 ℃培养条件下,在TTC培养基显色红色的为菌株BBH 12、BBH 16、BBH 20、BBH 25、BBH 31、BBH 37;在28 ℃培养条件下,在TTC培养基显色深红色的为菌株BBH 12和BBH 37;红色的为菌株BBH 3、BBH 9、BBH 16、BBH 20、BBH 31。颜色越深(如深红色)的菌落,其产酒精能力越强;颜色较浅的菌落(如粉色)产酒精能力次之;无显著颜色变化的菌落则可能产酒精能力较弱[29]。综合分析可知,Ⅰ类菌株和Ⅱ类菌株产酒精能力强于Ⅲ类。在28 ℃温度培养条件下,BBH 12、BBH 37、BBH 25菌株分别在Ⅰ类、Ⅱ类、Ⅲ类中产酒精能力最强;而在12 ℃温度培养条件下,以上3株菌株产酒精能力稍微减弱。因此,温度影响冰酒酵母菌株的产酒精能力,但影响并不显著,所以其在冰酒低温培养条件下也具有产酒精能力。
表2 酵母菌的产酒精能力测定结果
Table 2 Measurement results of alcohol production capacity of yeast strains

分类菌株编号12 ℃28 ℃颜色均匀性颜色均匀性Ⅰ类BBH 3粉色均匀红色均匀BBH 6浅粉色不均匀浅粉色不均匀BBH 9粉色均匀红色均匀BBH 12红色均匀深红色均匀BBH 17浅粉色均匀粉色均匀BBH 20红色均匀红色均匀BBH 22浅粉色均匀粉色均匀BBH 32浅粉色均匀浅粉色不均匀Ⅱ类BBH 2浅粉色均匀粉色均匀BBH 15浅粉色均匀浅粉色不均匀BBH 16红色均匀红色均匀BBH 21浅粉色不均匀浅粉色不均匀BBH 37红色均匀深红色均匀BBH 38浅粉色不均匀浅粉色不均匀Ⅲ类BBH 7浅粉色均匀粉色均匀BBH 18浅粉色均匀浅粉色不均匀BBH 25红色均匀红色均匀BBH 31浅粉色均匀浅粉色均匀BBH 34无色—浅粉色不均匀
注:—表示无数据。
除了颜色深浅外,还可以观察颜色的均匀性,颜色均匀且稳定的菌落表明其产酒精能力较为稳定。由表2可知,在12 ℃培养条件下,除BBH 6、BBH 21、BBH 34、BBH 38菌株外,其他菌株在TTC培养基显色均匀;在28 ℃培养条件下,除BBH 6、BBH 15、BBH 18、BBH 21、BBH 32、BBH 34、BBH 38菌株外,其他菌株在TTC培养基显色均匀。说明培养温度影响冰酒酵母菌产酒精的稳定性,温度越高产酒精越不稳定。综合分析可知,Ⅰ类菌落中BBH 3、BBH 9、BBH 12、BBH 17、BBH 20、BBH 22;Ⅱ类菌落中BBH 2、BBH 16和BBH 37;Ⅲ类菌落中BBH 7、BBH 25和BBH 31,以上12株菌株的TTC培养基显色都是均匀的,在冰酒低温培养条件下表现出较稳定的产酒精性能。
2.3.3 酵母产酯性能
将酵母菌接种到产酯筛选培养基上,通过观察并记录培养基上形成透明圈的大小,评估并判定酵母菌产酯类物质的能力高低[32],19株酵母菌的产酯能力测定结果见表3。由表3可知,19株酵母菌均具有一定的产酯能力。在12 ℃培养条件下,在Ⅰ类菌落中BBH 12的D/d值显著高于其他菌株(P<0.05);在Ⅱ类菌落中BBH 37的D/d值高于BBH 16,并显著高于其他菌株(P<0.05);在Ⅲ类菌落中BBH 25的D/d值显著高于其它菌株(P<0.05);对比三类菌落可知,菌落直径 Ⅱ类>Ⅰ类>Ⅲ类;Ⅰ类和Ⅱ类透明圈直径和D/d值之间差异不明显,但均高于Ⅲ类,其中D/d值最大的5株菌种大小顺序为:Ⅰ类BBH 12>Ⅱ类BBH 37>Ⅱ类BBH 16>Ⅰ类BBH 20>Ⅲ类BBH 25。
表3 酵母菌的产酯能力测定结果
Table 3 Measurement results of ester production capacity of yeast strains

分类菌株编号12 ℃28 ℃透明圈直径(D)/cm菌落直径(d)/cmD/d值透明圈直径(D)/cm菌落直径(d)/cmD/d值Ⅰ类BBH 30.30±0.040.21±0.031.44±0.11bc0.53±0.100.33±0.081.64±0.18bcBBH 60.25±0.050.19±0.021.29 ±0.13cd0.49±0.090.29±0.091.74±0.31bcBBH 90.28±0.010.19±0.011.47±0.03b0.52±0.080.32±0.081.68±0.17bcBBH 120.40±0.070.23±0.051.75±0.05a0.76±0.070.35±0.052.22±0.17aBBH 170.24±0.050.17±0.021.45±0.16bc0.54±0.120.31±0.061.71±0.06bcBBH 200.27±0.020.18±0.021.53±0.03b0.61±0.060.34±0.071.83±0.22bBBH 220.24±0.030.17±0.021.39±0.02bcd0.53±0.080.32±0.091.70±0.20bcBBH 320.20±0.040.16±0.021.24±0.08d0.41±0.100.28±0.051.45±0.09cⅡ类BBH 20.41±0.040.28±0.031.44±0.05bc0.73±0.080.42±0.091.79±0.19bBBH 150.30±0.040.27±0.031.10±0.03e0.72±0.090.43±0.061.67±0.04bBBH 160.47±0.020.31±0.041.54±0.15ab0.90±0.040.47±0.071.92±0.20abBBH 210.37±0.070.29±0.031.26±0.13de0.69±0.090.41±0.061.68±0.07bBBH 370.56±0.050.34±0.031.62±.070a1.01±0.100.46±0.092.23±0.18aBBH 380.36±0.030.27±0.021.34±0.04cd0.81±0.100.45±0.111.85±0.23bⅢ类BBH 70.11±0.010.09±0.011.22±0.03c0.28±0.040.18±0.051.55±0.16abBBH 180.09±0.010.08±0.011.10±0.05d0.23±0.050.16±0.031.44±0.04bBBH 250.23±0.020.15±0.021.50±0.03a0.29±0.070.16±0.031.79±0.18aBBH 310.17±0.030.13±0.021.31±0.05b0.25±0.050.18±0.051.43±0.12bBBH 340.10±0.010.09±0.011.12±0.01d0.19±0.060.15±0.041.31±0.17b
注:不同小写字母表示差异显著(P<0.05)(下同)。
在28 ℃培养条件下,在Ⅰ类菌落中BBH 12的D/d值显著高其他菌株(P<0.05);在Ⅱ类菌落中BBH 37的D/d值高于BBH 16,并显著高于其他菌株(P<0.05);在Ⅲ类菌落中BBH 25的D/d值高于BBH 7,并显著高于其他菌株(P<0.05)。对比三类菌落可知,菌落直径 Ⅱ类>Ⅰ类>Ⅲ类;Ⅰ类和Ⅱ类透明圈直径差异不明显,但均高于Ⅲ类;Ⅱ类菌株的D/d值高于Ⅰ类和Ⅲ类,其中D/d值最大6株菌种大小顺序为:Ⅱ类BBH 37>Ⅰ类BBH 12>Ⅱ类BBH 16>Ⅱ类BBH 38>Ⅰ类BBH 20>Ⅲ类BBH 25=Ⅱ类BBH 2。
研究表明酵母菌株产酯能力较强,可能与其酯合成酶的活性较高和底物利用能力较强等有关,而透明圈的大小与酵母菌株的产酯能力呈正相关。综合分析可知,在2种培养温度条件下19株酵母菌均具有产酯能力,Ⅰ类菌株和Ⅱ类菌株产酯能力强于Ⅲ类,而菌株BBH 12、BBH 37、BBH 25分别在Ⅰ类、Ⅱ类、Ⅲ类中产酯能力最强,以上3株酵母菌株在冰酒低温培养条件下具有较好的产酯能力。
2.3.4 酵母产β-葡萄糖苷酶性能
将酵母菌接种到七叶灵培养基上,通过观察并记录培养基上形成显色圈的大小,评估并判定酵母菌的产β-葡萄糖苷酶能力强弱[33]。19株酵母菌的产β-葡萄糖苷酶能力测定结果见表4。由表4可知,BBH 2、BBH 6、BBH 9、BBH 16、BBH 20、BBH 22、BBH 32、BBH 34和BBH 38酵母菌菌株没有产β-葡萄糖苷酶能力。在12 ℃培养条件下,对比三类菌落的D/d值可知,Ⅲ类>Ⅰ类>Ⅱ类;其中菌株BBH 17、BBH 37、BBH 25分别在Ⅰ类、Ⅱ类、Ⅲ类中D/d值最大。在28 ℃培养条件下,对比三类菌落的D/d值可知,Ⅲ类>Ⅰ类>Ⅱ类;其中菌株BBH 12、BBH 21和BBH 25分别在Ⅰ类、Ⅱ类、Ⅲ类中D/d值最大。七叶灵培养基中的七叶苷在β-葡萄糖苷酶的作用下会被水解,生成七叶素,而七叶素会与培养基中的其他成分反应,形成黑色的化合物,说明显色圈越大,酵母菌产β-葡萄糖苷酶能力越强[34]。综合分析可知,在2个培养温度条件下10株酵母菌具有产β-葡萄糖苷酶能力,其中Ⅰ类BBH 12和BBH 17、Ⅱ类BBH 21和BBH 37、Ⅲ类BBH 25具有较好的产β-葡萄糖苷酶能力。
表4 酵母菌的β-葡萄糖苷酶能力测定结果
Table 4 Measurement results of β-glucosidase activity of yeast strains

分类菌株编号12 ℃28 ℃显色圈直径(D)/cm菌落直径(d)/cmD/d值显色圈直径(D)/cm菌落直径(d)/cmD/d值Ⅰ类BBH 30.96±0.140.29±0.073.31±0.25a1.26±0.160.36±0.083.50±0.31aBBH 120.78±0.120.25±0.113.34±0.90a1.28±0.180.37±0.133.94±1.98aBBH 170.89±0.100.27±0.073.38±0.51a1.19±0.170.31±0.033.80±0.37aBBH 6、BBH 9、BBH 20、BBH 22、BBH 32——————Ⅱ类BBH 150.65±0.090.38±0.081.73±0.24a0.89±0.160.46±0.091.95±0.05bBBH 210.76±0.100.31±0.122.61±0.62a1.44±0.140.49±0.123.04±0.60aBBH 370.83±0.130.33±0.102.63±0.45a1.18±0.270.41±0.102.85±0.13aBBH 2、BBH 16、BBH 38——————Ⅲ类BBH 70.43±0.100.11±0.023.92±0.15bc1.28±0.140.27±0.054.85±0.46aBBH 180.57±0.130.13±0.034.40±0.12b1.13±0.170.24±0.034.79±1.18aBBH 250.67±0.110.12±0.025.43±0.42a1.44±0.110.25±0.015.75±0.47aBBH 310.53±0.110.14±0.033.78±0.25c1.23±0.170.29±0.064.34±0.68aBBH 34——————
注:“—”表示未产β-葡萄糖苷酶。
综合19株酵母菌的产气、产酒精、产酯和产β-葡萄糖苷酶能力分析结果可知,BBH 12和BBH 37的产气、产酒精和产酯能力显著强于其他菌种;BBH 25次之,但其在Ⅲ类菌株中相对较强;BBH 25产酶能力显著强于其他菌种,BBH 12和BBH 37分别在Ⅰ类和Ⅱ类中产酶能力相对较强。因此,筛选BBH 12、BBH 37和BBH 25为综合能力最佳菌种,分别是Ⅰ类、Ⅱ类和Ⅲ类中的优选目标菌株,所以将3株菌种进行下一步的分子生物学鉴定和12 ℃低温培养条件下耐受性测定。
2.4 酵母菌菌株分子生物学鉴定
将筛选和纯化3株酵母菌株进行分子生物学鉴定,酵母菌PCR扩增电泳图结果如图7所示。将3株酵母菌产物DNA序列与BLAST系统进行对比,用MEGA 软件分析基因序列,构建了系统发育树见图8。如图8所示,BBH 12、BBH 25、BBH 37菌株分别为酿酒酵母、核果梅奇酵母(Metschnikowia aff.fructicola)、葡萄汁有孢汉逊酵母(Hanseniaspora uvarum)。

图7 酵母菌PCR 扩增电泳图
Fig.7 Electrophoresis of PCR amplification of yeast strains

图8 酵母菌的系统发育树
Fig.8 Phylogenetic tree of yeast strains
2.5 低温条件下酵母菌的耐受性
2.5.1 酵母菌的耐温度性能
冰酒酿造过程中发酵温度控制在10~15 ℃,该温度范围保持酵母适宜的活性,使得发酵过程缓慢而稳定,从而保持冰酒中的风味成分和口感[3]。对3株酵母菌进行耐温度性能研究,结果见图9。由图9可知,随着温度的升高,3株酵母菌株的OD600nm值均呈先上升后下降的趋势,菌株在4~36 ℃培养条件下OD600nm值均大于0.5;在44 ℃培养条件下OD600nm值≤0.3,说明3株酵母菌株均具有一定的耐低温度能力,而耐高温度能力较差。比较不同温度条件下OD600nm值可知,3株酵母菌12、20与28 ℃之间差异不显著(P≥0.05)。因此,3株酵母菌对低温环境(12~28 ℃)具有良好适应性,酵母菌株生长状况和细胞浓度是稳定的,具有较低的代谢速率和较低的不良风味物质产生量,如挥发酸。在冰酒酿造过程中,3株菌种发酵温度控制在12~28 ℃,有利于保持冰酒的甜润口感和避免不良风味物质产生。

图9 酵母菌的温度耐受性
Fig.9 Temperature tolerance of yeast strains
注:不同小写字母表示差异显著(P<0.05)(下同)。
2.5.2 酵母菌的耐糖性能
冰酒是一种独特的甜葡萄酒,酿造用葡萄汁含有极高含糖量(320~360 g/L,以葡萄糖计)。酵母菌的耐糖性能直接影响其转化效率、产风味物质的种类和数量,还关系到发酵过程的稳定性[3]。对3株酵母菌进行耐糖性能研究,结果见图10。由图10可知,随着糖浓度的升高,3株酵母菌株的OD600nm值均呈先上升后下降的趋势,菌株在糖质量浓度为150 g/L时,OD600nm值达到最大值。比较不同糖浓度条件下的OD600nm值可知,3株酵母菌的糖质量浓度50 g/L与150 g/L之间差异不显著(P≥0.05);糖质量浓度50~450 g/L培养条件下OD600nm值均大于0.5。因此,3株酵母菌对高糖环境具有良好适应性,并且在糖质量浓度50~150 g/L培养条件下,酵母菌株的生长状况和细胞浓度较为稳定。

图10 酵母菌的糖耐受性
Fig.10 Sugar tolerance of yeast strains
2.5.3 酵母菌的耐酒精性能
冰酒发酵过程中酒精体积分数一般是9%~11%。耐酒精能力强的菌株可使冰酒发酵更完全,从而确保葡萄汁中的糖分被充分转化,提高冰酒的酒精度和风味品质[35]。同时,耐酒精性能较强的酵母菌在发酵后期仍能活跃地代谢产生风味物质,从而赋予冰酒更加独特的风味特征[36]。对3株酵母菌进行耐酒精性能研究,结果见图11。由图11可知,随着酒精体积分数的升高,3株酵母菌株的OD600nm值呈下降的趋势。比较不同酒精条件下OD600nm值可知,3株菌株在酒精体积分数4%~12%培养条件下OD600nm值均大于0.5,而酒精体积分数≥16%培养条件下OD600nm值均显著降低。因此,3株酵母菌对高酒精环境不适应,但在冰酒发酵的酒精环境中,酵母菌株的生长状况和细胞浓度相对稳定。

图11 酵母菌的酒精耐受性
Fig.11 Alcohol tolerance of yeast strains
2.5.4 酵母菌的pH性能
不同种类的酵母菌对pH的适应性有所不同,适宜的pH有助于酵母菌的生长和繁殖[37]。对3株酵母菌进行耐pH性能研究,结果见图12。由图12可知,随着pH的升高,BBH 12酵母菌株的OD600nm值呈先上升后下降的趋势,BBH 25和BBH 37则呈上升的趋势。比较不同pH条件下OD600nm值可知,BBH 12酵母菌株最适pH值为4.0,BBH 25和BBH 37酵母菌株最适pH值为6.0,但均与pH 5.0之间差异不显著(P≥0.05);3株菌株在pH 3~6培养条件下OD600nm值均大于0.5。因此,在冰酒发酵环境中,BBH 12酵母菌株稳定生长pH值范围为4.0~5.0,BBH 25和BBH 37酵母菌株稳定生长pH值范围为5.0~6.0,3株酵母菌对低pH条件均具有一定耐受性。

图12 酵母菌的pH值耐受性
Fig.12 pH value tolerance of yeast strains
3 结论
本研究从北冰红冰酒中分离出天然酵母菌38 株(编号为BBH 1~BBH 38),根据菌落形态初步筛选出19株。通过WLN培养基的菌株表型特征进行分类,19株菌株属于Ⅰ类菌落共8株、Ⅱ类菌落共6株、Ⅲ类菌落共5株。对19株菌株的产气、产酯、产乙醇、产β-葡萄糖苷酶等性能进行分析,研究结果表明Ⅰ类中BBH 12和Ⅱ类中BBH 37的产气、产酒精和产酯能力显著强于其他17株菌种;而Ⅲ类BBH 25产气、产酒精和产酯能力弱于两者,但其在Ⅲ类菌株中相对较强;BBH 25产酶能力显著强于其他18株菌种,BBH 12和BBH 37分别在Ⅰ类和Ⅱ类中产酶能力相对较强。由此可知,获得综合性能优良的3株菌株分别为BBH 12、BBH 25和BBH 37。分子生物学技术鉴定结果显示,BBH 12、BBH 25和BBH 37为酿酒酵母、核果梅奇酵母、葡萄汁有孢汉逊酵母。3株酵母菌株对温度、酒精、糖、pH的耐受性均较好,并且在温度12~28 ℃、糖质量浓度50~150 g/L、酒精体积分数4%~12%和pH 4.0~6.0冰酒酿造条件下,酵母菌株保持稳定的生长状况和较高的细胞浓度。因此,3株酵母菌具备冰酒酿造的优良菌种特性,可为北冰红冰酒生产提供具有鲜明本土特色的高品质酵母资源。
[1] CHEN Y, ZHANG W, YI H, et al.Microbial community composition and its role in volatile compound formation during the spontaneous fermentation of ice wine made from Vidal grapes[J].Process Biochemistry, 2020, 92:365-377.
[2] MA Y, GUILBERT A, BÉNO N, et al.Exploring the effects of mixture composition factors and perceptual interactions on the perception of icewine odor:An olfactometer-based study[J].Food Chemistry, 2023, 429:136881.
[3] MA Y, XU Y, TANG K.Aroma of icewine:A review on how environmental, viticultural, and oenological factors affect the aroma of icewine[J].Journal of Agricultural and Food Chemistry, 2021, 69(25):6943-6957.
[4] LI M Y, PEI X X, SHI N, et al.Volatomic differences among Vitis amurensis cultivars and its hybrids with V.vinifera revealed the effects of genotype, region, and vintage on grape aroma[J].Food Research International, 2024, 191:114726.
[5] 潘雪婷. 北冰红酵母菌的优选及其酿造冰葡萄酒的品质研究[D].石家庄:河北科技大学, 2023.PAN X T.Optimization of Beibinghong yeast and its impact on the quality of ice wine production [D].Shijiazhuang:Hebei University of Science and Technology Dissertation, 2023.
[6] BELESSI C E, CHALVANTZI I, MARMARAS I, et al.The effect of vine variety and vintage on wine yeast community structure of grapes and ferments[J].Journal of Applied Microbiology, 2022, 132(5):3672-3684.
[7] MAS A, PORTILLO M C.Strategies for microbiological control of the alcoholic fermentation in wines by exploiting the microbial terroir complexity:A mini-review[J].International Journal of Food Microbiology, 2022, 367:109592.
[8] ENGLEZOS V, JOLLY N P, DI GIANVITO P, et al.Microbial interactions in winemaking:Ecological aspects and effect on wine quality[J].Trends in Food Science &Technology, 2022, 127:99-113.
[9] YU X C, XU J, LI Y P, et al.Isolation and screening of wine yeasts from grapes in Yalu River valley China for fermentation performance[J].American Journal of Biochemistry and Biotechnology, 2021, 17(3):338-345.
[10] CIOCH-SKONECZNY M, SATORA P, SKONECZNY S, et al.Biodiversity of yeasts isolated during spontaneous fermentation of cool climate grape musts[J].Archives of Microbiology, 2021, 203(1):153-162.
[11] CARRAU F, BOIDO E, RAMEY D.Yeasts for low input winemaking:Microbial terroir and flavor differentiation [J].Advances in Applied Microbiology, 2020, 111:89-121.
[12] MONNIN L, NIDELET T, NOBLE J, et al.Insights into intraspecific diversity of central carbon metabolites in Saccharomyces cerevisiae during wine fermentation[J].Food Microbiology, 2024, 121:104513.
[13] ROCA-MESA H, DELGADO-YUSTE E, MAS A, et al.Importance of micronutrients and organic nitrogen in fermentations with Torulaspora delbrueckii and Saccharomyces cerevisiae[J].International Journal of Food Microbiology, 2022, 381:109915.
[14] BORDET F, ROMANET R, BAHUT F, et al.Impact of Saccharomyces cerevisiae yeast inoculation mode on wine composition[J].Food Chemistry, 2024, 441:138391.
[15] FENG L, WANG J M, YE D Q, et al.Yeast population dynamics during spontaneous fermentation of icewine and selection of indigenous Saccharomyces cerevisiae strains for the winemaking in Qilian, China[J].Journal of the Science of Food and Agriculture, 2020, 100(15):5385-5394.
[16] HONG M N, LI J, CHEN Y W, et al.Impact of mixed non-Saccharomyces yeast during fermentation on volatile aroma compounds of Vidal blanc icewine[J].LWT, 2021, 145:111342.
[17] ![]() M, PU
M, PU K
K ROV
ROV A, ŽENI
A, ŽENI OV
OV K, et al.Novel insights into microbial community dynamics during the fermentation of Central European ice wine[J].International Journal of Food Microbiology, 2018, 266:42-51.
K, et al.Novel insights into microbial community dynamics during the fermentation of Central European ice wine[J].International Journal of Food Microbiology, 2018, 266:42-51.
[18] LIU S X, LOU Y, LI Y X, et al.Aroma characteristics of volatile compounds brought by variations in microbes in winemaking[J].Food Chemistry, 2023, 420:136075.
[19] GE Q, GUO C F, YAN Y, et al.Contribution of non-Saccharomyces yeasts to aroma-active compound production, phenolic composition and sensory profile in Chinese Vidal icewine[J].Food Bioscience, 2022, 46:101152.
[20] 李凯, 王金晶, 李永仙, 等.红芯火龙果酒酿酒酵母的筛选及鉴定[J].食品与发酵工业, 2019, 45(5):115-120.LI K, WANG J J, LI Y X, et al.Screening and identification of yeast strain for red pitaya wine fermentation[J].Food and Fermentation Industries, 2019, 45(5):115-120.
[21] 胡江南, 高熳熳, 马立娟, 等.葡萄酒发酵优良酵母的筛选、鉴定及应用[J].中国酿造, 2023, 42(7):43-50.HU J N, GAO M M, MA L J, et al.Screening, identification and application of superior yeast strains for wine fermentation[J].China Brewing, 2023, 42(7):43-50.
[22] 王佳, 胡兰兰, 张军翔, 等.高产β-葡萄糖苷酶野生酵母的筛选及产酶能力差异性分析[J].中国酿造, 2018, 37(2):50-53.WANG J, HU L L, ZHANG J X, et al.Screening of wild yeast with high yield β-glycosidase and difference analysis of the enzyme production ability[J].China Brewing, 2018, 37(2):50-53.
[23] 李亚辉, 梁颖, 王英, 等.枸杞内生酵母菌的筛选及其发酵特性研究[J].中国酿造, 2019, 38(4):121-125.LI Y H, LIANG Y, WANG Y, et al.Screening and fermentation performances of endogenous yeast from wolfberry[J].China Brewing, 2019, 38(4):121-125.
[24] 闫兴敏, 姜娇, 高辉, 等.优良本土酿酒酵母的酿酒特性及产香能力初析[J].食品与发酵工业, 2022, 48(4):62-68.YAN X M, JIANG J, GAO H, et al.Oenological properties of superior indigenous Saccharomyces cerevisiae and their production of volatile compounds[J].Food and Fermentation Industries, 2022, 48(4):62-68.
[25] 徐丽萍. 泸型大曲中产酯酵母的筛选鉴定及产酯条件优化[J].中国酿造, 2016, 35(2):74-78.XU L P.Screening and identification of ester-producing yeast in Luzhou Daqu and optimization of ester production conditions[J].China Brewing, 2016, 35(2):74-78.
[26] 赵林果, 孟鹏, 李丽娟, 等.利用七叶灵显色技术检验和判断β-葡萄糖苷酶的研究[J].食品与发酵工业, 2008, 34(12):163-166.ZHAO L G, MENG P, LI L J, et al.Detection and identification of β-glucosidase with esculin as substrste[J].Food and Fermentation Industries, 2008, 34(12):163-166.
[27] PALLMANN C L, BROWN J A, OLINEKA T L, et al.Use of WL medium to profile native flora fermentations[J].American Journal of Enology and Viticulture, 2001, 52(3):198-203.
[28] 黄英子. 冰酒发酵过程中酵母菌的多样性及动态变化研究[D].杨凌:西北农林科技大学, 2023.HUANG Y Z.Diversity and dynamic change of yeasts during icewine fermentation[D].Yangling:Northwest A&F University, 2023.
[29] 曹云, 曹文涛, 王晓丹, 等.耐高温高产酒精酵母菌的筛选鉴定及特性研究[J].食品与发酵科技, 2023, 59(1):83-89.CAO Y, CAO W T, WANG X D, et al.Screening, identification and characterization of thermotolerant yeast strains with high-yield of alcohol[J].Food and Fermentation Science &Technology, 2023, 59(1):83-89.
[30] ZHANG B Q, SHEN J Y, DUAN C Q, et al.Use of indigenous Hanseniaspora vineae and Metschnikowia pulcherrima co-fermentation with Saccharomyces cerevisiae to improve the aroma diversity of vidal Blanc icewine[J].Frontiers in Microbiology, 2018, 9:2303.
[31] 王琪, 蔡建, 高秀, 等.黄泡野生酵母菌的筛选鉴定及其发酵性能研究[J].中国酿造, 2024, 43(6):182-188.WANG Q, CAI J, GAO X, et al.Screening, identification and fermentation performance of wild yeasts from Rubus pectinellus Maxim[J].China Brewing, 2024, 43(6):182-188.
[32] XIE G F, WANG L, GAO Q K, et al.Microbial community structure in fermentation process of Shaoxing rice wine by Illumina-based metagenomic sequencing[J].Journal of the Science of Food and Agriculture, 2013, 93(12):3121-3125.
[33] 高娉娉. 高产β-葡萄糖苷酶本土优良非酿酒酵母菌株筛选及应用效果评价[D].兰州:甘肃农业大学, 2022.GAO P P.Evaluation of the selection and application of indigenous high β-glucosidase activity non-Saccharomyces yeast[D].Lanzhou:Gansu Agricultural University, 2022.
[34] EDBERG S C, TREPETA R W, KONTNICK C M, et al.Measurement of active constitutive β-D-glucosidase (esculinase) in the presence of sodium desoxycholate[J].Journal of Clinical Microbiology, 1985, 21(3):363-365.
[35] SYNOS K, REYNOLDS A G, BOWEN A J.Effect of yeast strain on aroma compounds in Cabernet franc icewines[J].LWT - Food Science and Technology, 2015, 64(1):227-235.
[36] GE Q, GUO C F, ZHANG J, et al.Effects of simultaneous co-fermentation of five indigenous non-Saccharomyces strains with S.cerevisiae on vidal icewine aroma quality[J].Foods, 2021, 10(7):1452.
[37] 仇小妹, 王英, 董明盛,等.优良降酸酵母菌的筛选及发酵性能[J].食品科学, 2014, 35(5):160-164.QIU X M, WANG Y, DONG M S, et al.Strain improvement of saccharomyces cerevisiae for acid degradation and fermentation performance of the screened strain[J].Food Science, 2014, 35(5):160-164.